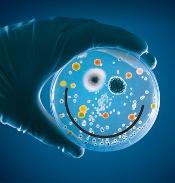

Les
LE FOOT A-T-IL UN IMPACT SUR LE CERVEAU ?
Pression au travail, transports bondés, problèmes administratifs…

Les
LE FOOT A-T-IL UN IMPACT SUR LE CERVEAU ?
Pression au travail, transports bondés, problèmes administratifs…
PSYCHOLOGIE COMMENT
APPRENDRE
RÉELLEMENT
DE SES ERREURS
DICTATEURS
LES DÉMOCRATIES
PEUVENT-ELLES
RÉSISTER ?
BUREAU
OPEN SPACE, FLEXOFFICE : QUEL IMPACT
SUR NOTRE
BIEN-ÊTRE ?
Les techniques pour réguler ses émotions au jour le jour










 photo : © Christophe Abramowitz / RF
photo : © Christophe Abramowitz / RF
N° 166

p. 16-17
Julie Buron
Postdoctorante au Département des neurosciences fondamentales à l’université de Lausanne, elle étudie le fonctionnement de notre système nerveux autonome.

p. 36-43
Gérald Delelis
Maître de conférences en psychologie sociale à l’université de Lille, membre du Laboratoire de sciences cognitives et a ectives de l’université de Lille et du CNRS (SCALab), il travaille sur les di érentes formes de régulation émotionnelle.

p. 44-47
Frédéric Fanget
Médecin psychiatre, il organise depuis plusieurs années des ateliers d’a rmation de soi pour apprendre à exprimer ses besoins sans s’énerver.

p. 78-84
Lauren Young
Rédactrice en chef adjointe au magazine Scientific
American, chargée de la santé et de la médecine, elle a enquêté sur les conséquences pour le cerveau des chocs à la tête lors des compétitions de football.

Rédacteur en chef
On peut se demander, certains jours. S’il n’y aurait pas de quoi péter un plomb. Un câble. Ou un boulon. C’est selon.
Les scientifques ont très bien repéré ce qui nous fait disjoncter. Le premier de tous les détonateurs, c’est l’ordinateur qui plante. L’imprimante qui ne veut pas imprimer. En gros, l’informatique qui refuse d’exécuter ce qu’on lui dit de faire. Mais il y a aussi les services après-vente ou les hotlines qui vous renvoient d’un service à l’autre sans aucune logique. Et puis les politiques qui ne tiennent pas leurs promesses, ou le type qui vous marche sur les pieds dans une rame de métro bondé. Dans l’ensemble, les occasions ne manquent pas. Alors il fallait bien vous proposer des solutions. Vous les trouverez dans notre dossier central.
Mais péter les plombs, ça arrive aussi aux scientifques, et pas des moindres ! Les Prix Nobel, par exemple, disjonctent parfois complètement : certains se mettent à raconter n’importe quoi, persuadés d’avoir toujours raison – c’est le syndrome du prix Nobel (voir page 52)
Le foot tape aussi sur le système, dirait-on, avec des données que nous vous présentons, montrant que le cerveau ricoche dans la boîte crânienne lors d’impacts à la tête. Ce sera la fête aux neurones pendant l’Euro de foot du mois de juin.
Finalement, c’est parfois une décharge électrique qui fait le plus de bien au cerveau. Après avoir longtemps souffert d’une image très négative, les électrochocs font leur grand retour, avec des taux de guérison élevés chez les grands dépressifs (page 24). Heureusement qu’on a rendu cette méthode moins agressive et plus ciblée. Mais ça aussi, on vous laisse le découvrir… £
N° 166 JUIN 2024

p. 6 ACTUALITÉS
Contre la douleur, l’anxiété et la déprime… des câlins !
Vieillir comme un superager
Le microbiote stimule l’immunité des tout-petits
Grossesse et antidépresseurs : quel impact sur le bébé ?
Mmmh… Les bonnes frites !
Des règles synchro avec la Lune ?
p. 16 FOCUS
Malaise : quand le cœur dit stop au cerveau
Quand on fait un malaise, le cœur commande au cerveau de se mettre en veilleuse !
Julie Buron
p. 18 PSYCHIATRIE
Un « facteur p » à l’origine des maladies mentales ?
Dépression, schizophrénie ou TOC se concentreraient chez les mêmes personnes. D’où l’hypothèse d’un facteur de vulnérabilité générale, le « facteur p ».
Ingrid Wickelgren
p. 24 NEUROSCIENCES
Malgré leur mauvaise réputation, les électrochocs sont souvent e caces contre la dépression – et on a peut-être compris pourquoi.
Elizabeth Landau
p. 28 MICROBIOTE
Comment notre ventre façonne notre personnalité
Les di érences de personnalité entre individus pourraient être dues en partie à la composition de leur flore intestinale.
Christian Wolf
p. 36 PSYCHOLOGIE
OBJECTIF : GARDER SON CALME
Les occasions de s’énerver ne manquent pas. Comment enclencher les bonnes pensées qui régulent l’émotion ?
Gérald Delelis
p. 44 SCIENCES COGNITIVES « EXPRIMER SES BESOINS APAISE LA COLÈRE »
La colère révèle l’existence d’un obstacle à nos besoins ou nos souhaits.
Les formuler change tout.
Entretien avec Frédéric Fanget
p. 48 COMPORTEMENT QUAND LA RAGE LIBÈRE
Dans certains cas, s’énerver dope les performances. Mais cette stratégie est à prendre avec des pincettes.
Heather Lench
Ce numéro comporte un encart d’abonnement Cerveau & Psycho, broché en cahier intérieur, sur toute la di usion kiosque en France métropolitaine. Il comporte également un courrier de réabonnement, posé sur le magazine, sur une sélection d’abonnés. En couverture : © Memo Angeles/Shutterstock
p. 6-33

p. 52-76


p. 78-91


p. 92-97

p. 52 PSYCHOLOGIE COMPORTEMENTALE
Le syndrome du prix Nobel
Géniaux, célébrés… puis à côté de la plaque : pourquoi certains lauréats débloquent-ils ?
Nicolas Gauvrit et Hayet Zeghiche
p. 58 PSYCHOLOGIE
L’enfance du crime
Le passé des criminels porte souvent la trace de carences a ectives profondes.
Tiphaine Pioger
p. 64 RAISON ET DÉRAISON
États prédateurs : comment les arrêter ?
La théorie des jeux permet de répondre en partie à cette question.
Nicolas Gauvrit
p. 68 NEUROLOGIE
Foot : gare aux têtes !
Pour le cerveau, le foot n’est pas sans risque.
Lauren Young
p. 74 L’ENVERS DU DÉVELOPPEMENT PERSONNEL
Apprenons-nous vraiment de nos erreurs ?
Cette idée aboutit de plus en plus à dire n’importe quoi.
p. 78 BIEN-ÊTRE
l’« open space »
Fatigant, nuisible à la communication, l’open space est un échec. Des solutions urgentes sont attendues - et parfois imaginées.
George Musser
p. 86 L’ÉCOLE DES CERVEAUX

JEAN-PHILIPPE LACHAUX
rap des maths dope les apprentissages
Un prof de maths rappe sur des opérations d’arithmétique, et ça marche ! Il active deux circuits neuronaux de traitement du langage dans le cerveau de ses élèves...
p. 90 LA QUESTION DU MOIS
D’où vient l’odeur des ados ?
Leur sueur contient des acides carboxyliques aux odeurs d’herbe coupée, de fromage ou de musc de chèvre.
Joanna Thompson
p. 92 SÉLECTION DE LIVRES
Schizophrénie et génétique
Qu’est-ce que l’intelligence ?
Deux têtes
Science et école : ensemble pour mieux apprendre
Pourquoi nous rêvons
La Santé mentale de mon enfant
p. 94 NEUROSCIENCES ET LITTÉRATURE

SEBASTIAN DIEGUEZ
« L’Établi » : quand les humains obéissent aux machines
Dans les entrepôts d’Amazon, les humains sont commandés par des machines.
Une robotisation dont les prémices se lisaient déjà dans le récit du sociologue
Robert Linhart, L’Établi, il y a presque cinquante ans…

Les électrochocs sont en général vus comme un traitement barbare. Mais ils sont souvent e caces contre les troubles dépressifs majeurs. On a peut-être trouvé l’explication à leur pouvoir thérapeutique.

EN BREF
£ La thérapie par électrochocs (ECT) et son équivalent avec des champs magnétiques (la MST) améliorent souvent les symptômes dépressifs de patients résistants à tout autre traitement.
£ Selon des études récentes, la crise épileptique provoquée par ces techniques augmenterait le « bruit de fond » cérébral en rétablissant l’équilibre entre l’excitation et l’inhibition des neurones.
£ La compréhension de ces mécanismes devrait permettre d’aboutir à une technique plus précise, moins stressante et plus confortable pour les patients.
Quand on prononce le mot « électrochoc », des images de méthodes barbares, voire de torture, viennent aussitôt à l’esprit. On pense au flm Vol au-dessus d’un nid de coucou, de Miloš Forman, où le traitement par électroconvulsivothérapie (son terme technique médical, en abrégé ECT) est utilisé comme une punition sadique. D’autant que le principe de cette méthode consiste à envoyer des courants électriques dans le cerveau pour provoquer de brèves crises d’épilepsie… Autant dire que cette pratique n’a pas bonne presse.
Et pourtant. Pour les patients atteints de dépression profonde chez qui les
médicaments habituels se sont révélés inopérants, c’est parfois une planche de salut. Ainsi, des études ont montré que 50 à 70 % des personnes souffrant d’un trouble dépressif majeur voient leurs symptômes diminuer après une séance d’ETC. En comparaison, les médicaments qui modifent la chimie du cerveau n’aideraient, selon une étude publiée en 2018, qu’au plus 40 % d’entre elles. Alors, d’où vient le pouvoir de ce traitement particulier ?
LE BRUIT DE FOND DU CERVEAU
AUGMENTE
Malgré des décennies d’utilisation, les scientifiques ne savent toujours pas, aujourd’hui, comment cette technique thérapeutique modife la biologie du cerveau. Bradley Voytek, neuroscientifque à l’université de Californie à San Diego, raconte qu’un psychiatre lui a un jour dit que la thérapie « réinitialise le cerveau ». Une réponse loin d’être suffsante, pour lui.
L’ÉTONNANT POUVOIR DES ÉLECTROCHOCS
Aussi a-t-il voulu en avoir le cœur net. Il y a environ neuf ans, Bradley Voytek a fait équipe avec la psychiatre Maryam Soltani, de la même université, et ses collègues, qui recueillaient alors des données d’électroencéphalogramme chez des patients soumis à une ECT pour enrayer un trouble dépressif majeur. Les chercheurs ont alors posé des électrodes à l’avant de la tête des sujets pour enregistrer l’activité électrique de leur cerveau, avant et après le traitement par électrochocs.
Dans un cerveau sain, on voit apparaître spontanément des oscillations répétitives de l’activité électrique, les ondes cérébrales. Ainsi, les ondes alpha, de fréquences comprises entre 8 et 12 hertz, ont tendance à surgir dans les états de relaxation profonde ou quand nous dormons. Des recherches antérieures ont également établi un lien entre ces fameuses ondes et la dépression, de sorte que Maryam Soltani et Bradley Voytek ont fait l’hypothèse que le traitement par ECT pouvait les modifer. Mais l’analyse des données obtenues sur les deux premiers patients a révélé tout autre chose : une augmentation du « bruit de fond » des neurones, encore appelé « activité apériodique ». De quoi s’agit-il ? Tandis que les ondes cérébrales représentent une activité clairement discernable

Cet article a initialement paru dans Quanta Magazine, sous le titre « Brain’s “background noise” may explain value of shock therapy ».
50 À 70 %
et périodique, avec des hauts et des bas réguliers, l’activité apériodique est quant à elle désordonnée, et représente plutôt des décharges aléatoires des neurones. Bien que l’activité apériodique ne produise pas de confguration électrique évidente lisible par les appareils d’électroencéphalographie, les deux chercheurs ont mis au point des outils statistiques qui révèlent sa structure apériodique sous-jacente. Et c’est une hausse de cette dernière qu’ils ont observée sur les enregistrements cérébraux des patients de Maryam Soltani ayant été traités par électrochocs.
Lors d’une première étude portant sur 9 sujets publiée en novembre 2023 dans Translational Psychiatry, les scientifques ont ainsi rapporté que l’activité apériodique augmentait après l’ECT. Ensuite, lors d’une étude complémentaire, ils se sont penchés sur des ensembles de données plus importants, collectés auprès de 22 personnes ayant reçu cette même thérapie ainsi que 23 individus ayant reçu un traitement par magnétosismothérapie (MST), une technique similaire qui utilise des champs magnétiques à la place des courants électriques. Et là encore, les résultats ont révélé que l’activité apériodique avait tendance à s’amplifer.
Qu’est-ce qui explique ce phénomène ? On pense aujourd’hui que le bruit de fond neuronal serait lié à l’équilibre entre des mécanismes d’excitation et d’inhibition dans le cerveau. Précisons ces notions : lorsqu’un neurone reçoit un signal électrique d’un autre neurone, il est soit excité, ce qui augmente sa probabilité de s’activer et d’émettre à son tour un signal électrique, soit inhibé, ce qui réduit cette même probabilité. Or en 2017, Bradley Voytek et ses collègues ont publié une étude dans la revue NeuroImage où ils suggéraient qu’une hausse de l’activité apériodique correspondrait à une augmentation de l’inhibition…
RÉTABLIR L’ÉQUILIBRE
ENTRE EXCITATION ET INHIBITION
Par conséquent, l’ECT aurait pour effet d’augmenter l’inhibition neuronale, et cet effet inhibiteur serait parfois associé à une diminution des symptômes de la dépression. « L’ECT serait capable de réduire les troubles dépressifs graves en rétablissant des niveaux d’inhibition normaux dans le cortex frontal », ont écrit Sydney Smith et ses collègues.
Reste que l’équipe de recherche n’a pas conçu ces expériences pour prouver l’existence d’un lien entre activité apériodique et dépression – ce lien était une hypothèse antérieure à ces travaux. Il est possible que ce dernier existe, mais « le démontrer est une autre histoire », commente K. Ranga Rama Krishnan, conseiller principal du président-directeur général du système de santé de l’université Rush, à Chicago, qui a passé plusieurs décennies à superviser un programme incluant l’ECT à l’université Duke et qui n’a pas été impliqué dans ces études. « Afn de montrer ce lien de manière défnitive, il faudrait que les chercheurs étudient une population de patients beaucoup plus importante et qu’ils suivent un plan expérimental délibéré. Néanmoins, ces articles constituent un pas dans la bonne direction. »
Selon Sarah Lisanby, directrice de l’unité de neuromodulation non invasive à l’Institut américain de la santé mentale, qui n’a pas non plus participé à ce travail, un autre élément important à retenir est que les « versions » électrique et magnétique des thérapies ont produit des changements similaires de l’activité apériodique. « Cela suggère que ce ne sont pas les courants électriques de l’ECT qui atténueraient les symptômes de la dépression, mais plutôt la crise d’épilepsie qu’ils provoquent. »
D’ailleurs, la chercheuse a montré récemment que la MST est aussi effcace que l’ECT,
Le bruit de fond du cerveau augmente après la thérapie par électrochocs, ce qui pourrait expliquer son e cacité contre les graves dépressions.
mais qu’elle s’accompagne d’effets secondaires à la fois moins nombreux et moins lourds [les traitements sont appliqués sous anesthésie générale, mais il arrive que des maux de tête, courbatures ou raideurs musculaires, voire des nausées, se produisent après les interventions, ndlr]. Cependant, alors que l’ECT est disponible en pratique clinique, la MST n’a toujours pas été approuvée par la Food and Drug Administration (FDA) et n’est utilisée à ce jour qu’à des fns de recherche.
VERS DES ÉLECTROCHOCS PLUS CONFORTABLES ET MOINS STRESSANTS
Sydney Smith et Bradley Voytek estiment que si leurs résultats sont confrmés lors de futures études, l’activité apériodique du cerveau pourrait devenir un marqueur utile aux médecins pour déterminer quels patients devraient le plus bénéfcier de ces traitements par convulsions. Alors que l’ECT représente actuellement « comme un coup de marteau » sur la tête quand on l’applique, l’étude de ses mécanismes pourrait éventuellement conduire à une technique plus précise, moins stressante et plus confortable pour les patients, a déclaré le neuroscientifque.
Au-delà des applications cliniques, ces recherches aideront peut-être les personnes atteintes de dépression à comprendre ce qui se passe dans le cerveau lors de l’ECT et en quoi cette thérapie pourrait leur être proftable. « Au moins une partie de la conversation avec les patients sur les risques et les avantages du traitement revient à leur expliquer : “Voici ce que nous essayons de changer dans votre cerveau”, selon Sydney Smith. Ce qui est mieux que de leur dire que la thérapie agit simplement comme “un bouton de réinitialisation”… » £
Z.-D. Deng et al., Clinical outcomes of magnetic seizure therapy vs electroconvulsive therapy for major depressive episode : A randomized clinical trial, Jama Psychiatry, 2024
S. E. Smith et al., Clinical EEG slowing induced by electroconvulsive therapy is better described by increased frontal aperiodic activity, Translational Psychiatry, 2023.
S. E. Smith et al., Magnetic seizure therapy and electroconvulsive therapy increase aperiodic activity, Translational Psychiatry, 2023
A. T. Hill et al., Modulation of functional network properties in major depressive disorder following electroconvulsive therapy (ECT) : A restingstate EEG analysis, Scientific Reports, 2020.



Mardi 14 mai à 14h30
À quoi pensent les bébés ?
Que savons-nous de l’éveil des sens des tout-petits ? Les travaux de chercheurs en neurosciences, ergothérapeutes, éducateurs et artistes soulignent l’importance des expériences en plein air. Opportunités uniques d’apprentissage et de découvertes, elles permettent de riches stimulations sensorielles et favorisent l’épanouissement des bébés. Alors, sortez les frimousses !
C’est la question à laquelle tentent de répondre les chercheurs des babylabs, grand réseau de recherches et d’expérimentations sur le développement des bébés. Quels champs explorent-ils ? Que nous apprennent ces travaux sur l’éveil des sens des tout-petits ?
Avec Marie Palu, ergothérapeute, Jessica Dubois, chercheuse en neurosciences, Anne-Caroline Fievet, chercheuse en neuroscience et Viviane Huet, technicienne en neurosciences.
Mardi 21 mai à 14h30
Tous dehors !
Projection-débat autour du documentaire Tous dehors ! de Anne Jochum, 57 min, 2023.
Le développement de l’enfant nécessite des interactions multiples avec le monde du vivant. Quels sont les impacts de notre sédentarité en intérieur sur la santé des plus jeunes ? Un plaidoyer pour s’égayer en plein air !
Avec Élise Mareuil, éducatrice de jeunes enfants, Anne Jochum, réalisatrice et Jean Epstein, psychosociologue.
Gratuit sur réservation
Retrouvez toute notre programmation ici :

Mardi 28 mai à 14h30
Le bébé, un animal social
Comment l’art, l’environnement direct dans lequel il évolue, son immersion dans la nature et ses échanges avec les adultes participent-ils au développement du bébé ? Scientifques et artistes partagent leurs expériences de terrain.
Avec Claire Grolleau, microbiologiste et présidente de l’association Label Vie, Louise Bouché, chargée de mission chez Label Vie et Vincent Vergone, artiste plasticien, fondateur de la compagnie Les demains qui chantent.
En partenariat avec Avec le soutien de
SOMMAIRE
p. 36
Objectif : garder son calme
p. 44 Interview
« Exprimer ses besoins apaise la colère »
p. 48
Quand la rage libère
La colère monte. Manifestations qui dégénèrent, quidams qui agressent des guichetiers ou des médecins, parents d’élèves furieux, invectives sur les réseaux sociaux, rixes entre jeunes… Que se passe-t-il dans notre société ?
Le cerveau humain « disjoncte » quand il est frustré. Autrement dit, quand il accumule trop de stress et de contrariétés. C’est ainsi que les rythmes de vie, la charge mentale, le stress, les incertitudes sur l’avenir peuvent amener chacun au point de rupture où il perdra le contrôle de lui-même. Mais un autre facteur nous est inhérent : notre cerveau perd le contrôle quand il n’arrive pas à gérer les contrariétés, qu’il démarre au quart de tour pour trois fois rien. Sur ce plan, chacun peut développer sa tolérance à la frustration, et s’entraîner à la régulation émotionnelle. Ce dossier propose des moyens d’y arriver, notamment en apprenant à réévaluer ses propres ressentis. Car ce ne sont pas les situations qui nous font réagir, mais la façon dont nous les interprétons. C’est pourquoi le regard que nous portons sur les événements peut faire de nous, soit des bombes prêtes à exploser, soit des individus capables d’exprimer leurs besoins posément. C’est bon signe : parfois, la cognition l’emporte sur l’émotion.
Sébastien Bohler
Entre la pression au travail, les soucis administratifs et les contrariétés du quotidien, les occasions sont multiples de perdre ses nerfs. Pour ne pas craquer, les psychologues ont heureusement trouvé des stratégies cognitives pour vous aider à faire retomber la pression.
Par Gérald Delelis, maître de conférences en psychologie sociale à l’université de Lille, membre du Laboratoire de sciences cognitives et a ectives de l’université de Lille et du CNRS (SCALab).
BREF
£ Face aux situations qui nous mettent hors de nous, plusieurs stratégies sont envisageables.
£ Premièrement, serrer les dents et « contrôler » l’émotion à tout prix. Pas très bon pour le stress et la santé.
£ Deuxième option : remettre l’événement en perspective. Bon choix : l’émotion est relativisée et s’apaise d’elle-même.
£ La méditation de pleine conscience est un autre outil de choix, à pratiquer régulièrement.
£ Veiller à développer une bonne estime de soi est enfin protecteur contre les « coups de sang ».
Qui n’a jamais perdu ses nerfs lors d’une dispute avec son partenaire, quand il se sentait incompris, méprisé, voire humilié ? De retour d’une journée difficile, quand tout reste à faire à la maison et que les enfants hurlent en tous sens, quel parent ne s’est pas surpris à hausser la voix et à perdre le contrôle de ses émotions ? Ou bien, lors de négociations salariales, combien de fois les parties adverses ne se sont pas invectivées ? Même dans les débats parlementaires, les pertes de sang-froid ne sont plus rares et la violence verbale semble s’être répandue ces derniers temps. La colère gronde, et parfois explose, comme dans les émeutes de juin 2023, lors des manifestations d’agriculteurs, dans les affrontements entre forces de l’ordre et lycéens, ou avec les opposants à certaines mesures du gouvernement. Mais c’est encore sur les réseaux sociaux que tout le monde est probablement le plus « en colère », au point d’en faire un étendard, une justifcation à des propos hostiles, si ce n’est à des agressions d’une rare violence. Que se passe-t-il avec ce sentiment, comment le sentir monter et arriver à le raisonner avant qu’il ne ravage tout sur son passage ?
La colère est une des six grandes émotions de base, avec la joie, la tristesse, la peur, le dégoût et la surprise. Savoir comment l’apaiser ou la moduler renvoie donc à la question de la régulation émotionnelle. Une aptitude qui peut être développée, et dont l’importance est cruciale dans nos vies. Vous,
DOSSIER COMMENT GÉRER SA COLÈRE
OBJECTIF : GARDER SON CALME
moi, nous tous vivons quotidiennement des épisodes émotionnels face auxquels nous devons mettre en œuvre des réponses adaptées aux circonstances et au cadre social. Dès lors, la question de la (bonne) régulation des émotions paraît centrale pour la maîtrise des mécanismes qui régissent ces réponses émotionnelles. En particulier nos réactions de colère.
POURQUOI SE MET-ON EN COLÈRE ?
Les émotions sont le résultat d’une séquence allant de la perception d’un stimulus dans l’environnement (par exemple, une critique émise par autrui) à l’expérience d’une émotion, en passant par la sensation de changements internes liés au stimulus (accélération cardiaque, fourmillements) et la qualifcation du ressenti par une étiquette émotionnelle – la colère. Le point de départ va donc être un stimulus, un contexte, ou une accumulation de faits que notre organisme va interpréter comme une menace ou la rupture d’un équilibre. Il peut s’agir d’un projet qui piétine au travail, de diffcultés à mobiliser une équipe pour atteindre un objectif, d’une inquiétude sur votre couple, de soucis administratifs ou fnanciers qui s’accumulent, et dont la solution tarde à se dessiner… Ainsi, cette émotion va naître lorsque nous faisons face à des situations anxiogènes dans lesquelles, justement, nous sommes en absence de contrôle, parfois de soutien, et de temps ou d’énergie pour ressentir et agir autrement. En ce sens, la colère est réactionnelle, elle nous énergise pour notre défense et nous permet de nous affrmer – ou de détecter des défs lorsqu’elle est exprimée par autrui.
La réaction est alors facilement reconnaissable et s’accompagne de signes comme la contraction des muscles des sourcils, le rétrécissement des yeux, une augmentation de la fréquence cardiaque, une élévation du volume de la voix et une tension générale des muscles de l’organisme, comme pour préparer au combat. C’est l’avantage de la colère : en offrant un répertoire d’actions toutes prêtes, elle apparaît facilement à celui qui la vit comme une solution défensive et de reprise de contrôle sur le cours des événements. Elle permet aussi de montrer clairement notre vécu interne aux autres et parfois de les y faire participer dans un jeu de dominance sociale.
Les stimuli capables d’enclencher cette cascade de réactions sont nombreux autour de nous : exigence de performance dans le milieu professionnel, nécessité affchée de s’affrmer, alors même que nombre de choses restent incertaines et incontrôlables, et cela dans un contexte
d’insécurité individuelle, d’augmentation du déclassement et des inégalités, de menaces terroristes et de tensions internationales, le tout sur fond de dégradation de notre planète : l’ensemble compose le cocktail détonant propice à la montée de l’anxiété et à l’expression de la colère.
En effet, on sait que l’anxiété mène à un ressenti d’insécurité et nous conduit à nous focaliser sur les informations menaçantes. Selon le psychologue Andrew Mathews, du King’s College de Londres, nous percevons alors une menace contre notre personne et développons une attention particulière à ce que nous considérons comme la source de la menace : un collègue, un patron, le gouvernement, etc. Nos ressources cognitives deviennent moins disponibles pour prendre en compte la totalité des informations qui nous entourent et se « resserrent » sur la menace potentielle. Notre attention est alors régulièrement attirée par les signaux anxiogènes (on pense notamment au rôle joué par les médias) et nous restons en alerte, hautement réceptifs à ces signaux.
Si l’on ajoute un état de précarité et d’exclusion sociale, ou bien un sentiment d’infériorité vis-àvis d’autres personnes plus favorisées, tout ce qui gravite autour de nous peut devenir prétexte à agression. Ainsi, en 2009, le psychologue Nathan DeWall, de l’université du Kentucky, à Lexington, a mené des expériences consistant à faire ressentir un sentiment d’exclusion à des participants, et à tester ensuite leur réaction face à des visages à l’expression neutre : ils avaient tendance à leur attribuer un caractère hostile et leur comportement vis-à-vis des autres individus présents, y compris étrangers à l’expérience, devenait clairement plus agressif. Dans d’autres cas étudiés par les psychologues Jan-Willem van Prooijen et Karen Douglas, de l’université d’Amsterdam, ces situations de déclassement se traduisaient par la conviction que les autres personnes étaient malintentionnées et par une adhésion plus forte à des théories conspirationnistes. Le sentiment de perte de contrôle joue un rôle déterminant à cet égard, et on comprend pourquoi, dans un monde qui semble plus incertain, soumis à la compétition et aux inégalités, où il est plus diffcile de se projeter vers un avenir rassurant, l’impression de ne plus rien contrôler peut donner lieu… à des pertes de contrôle. Le nombre de parents qui surréagissent avec leurs enfants, ou de partenaires de couple qui cèdent à la fureur au lieu de chercher le compromis, nous rappelle que la colère ne vient pas de nulle part, et s’enracine dans le sentiment d’une menace plus ou moins diffuse.
Selon les psychologues Elizabeth Lemerise et Kenneth Dodge, de l’université du Kentucky, la réaction émotionnelle de colère est une tentative de (re)prise de contrôle face à des situations menaçantes, pour contrer les effets de la peur ou de l’anxiété. Cette notion s’appuie sur une série d’expériences menées à la fois sur des enfants et sur des adultes. En colère, les enfants face à un obstacle les empêchant d’accéder à ce qu’ils désirent multiplient les tentatives pour l’éliminer. Et des adultes confrontés, par exemple, à une conjoncture non maîtrisée (un embouteillage) manifestent des signes d’énervement, avec une hausse de la fréquence cardiaque et des tentatives de contournement ou de prises de risque pour récupérer en partie le contrôle de la situation et regagner le temps perdu.
Parfois, la colère surgit aussi en cas de peur, et semble s’opposer à cette émotion. Ainsi, le psychologue américain Robert Plutchik, pionnier des recherches sur les émotions, avait noté que les expressions de la peur et de la colère, aussi bien
Selon le psychologue
américain Robert Plutchik, les émotions peuvent être disposées sur un diagramme en fonction de leurs manifestations physiques et comportementales. La colère y est diamétralement opposée à la peur, aussi bien par les agissements (agressivité contre fuite) que par les mimiques faciales (sourcils levés contre sourcils froncés, etc.). Ce qui semble indiquer que la colère serait un a ect venant contrebalancer la peur.
sur les visages que dans les comportements, sont à l’opposé les unes des autres. Comme si la colère était un moyen de contrer les effets de la peur et de rétablir une forme d’équilibre, en mettant en œuvre des comportements et des expressions du visage qui signifent également à autrui les limites à ne pas dépasser.
De fait, des chercheurs comme Gerold Mikula et son équipe de l’université de Graz, en Autriche, ont montré que cette émotion est particulièrement vive et rapide lorsque nos buts sont contrariés, ou que l’on pense être victime d’une injustice ou d’une agression. Rapide, parce qu’être en colère, c’est se mettre en évidence, faire valoir ses droits, ce qui renvoie à un ressenti (provisoirement) positif. En soi, la colère peut donc être temporairement satisfaisante, parce qu’elle est un moyen d’évacuer l’angoisse et de s’affrmer, avec des effets positifs sur l’humeur selon certains chercheurs. Cette émotion reviendrait dans ce cas à une forme première de régulation évitant de garder sa frustration pour soi – avec des conséquences néfastes pour la personne elle-même et qui s’exprimerait par des ruminations (pourquoi n’ai-je rien dit quand untel m’a manqué de respect ?), mais délétères aussi pour sa relation à autrui sur le long terme (génératrice de nondits ou de distanciation).
Optimisme
Intérêt
Agressivité
Anticipation
Sérénité
Joie
Amour
Acceptation
Confiance
Extase Admiration Vigilance
Colère Rage Irritation
Ennui Dégoût
Soumission
Terreur Peur Appréhension
Pourtant, si elle permet l’évacuation primaire d’un trop-plein d’émotions, la colère est peu susceptible de promouvoir la négociation et le changement. Poser un cadre de revendications lorsqu’on est sous le coup de la rage et de la fureur est contre-productif et risque de susciter également de la colère en retour, jusqu’à amorcer une spirale tout aussi anxiogène que la source première de ce sentiment. Comment alors réguler au mieux nos émotions, notamment cette anxiété et cette colère qui en découlent souvent ?
C’est la troisième fois que, lors d’une réunion de travail, votre supérieur ne prend pas en compte vos remarques, voire y réagit avec condescendance, alors qu’il n’a même pas lu votre rapport. Vous savez qu’il ne serait pas bon de vous énerver, mais vous sentez la rage bouillir au fond de vous. Alors, vous vous contenez. Vous serrez les dents et vous efforcez de conserver un visage impassible. Mais en sortant de la salle de réunion, vous vous sentez rongé par la rancœur et l’injustice. Et en rentrant chez vous, vous ne cessez de vous faire le reproche : « J’aurais dû lui répondre, je me suis laissé faire, je ne peux m’en prendre qu’à moi-même. »
OBJECTIF : GARDER SON CALME
Face à une situation qui vous mettait à l’épreuve, vous avez réprimé l’émotion de colère. On parle de « suppression émotionnelle ». Un choix parfois effcace sur le moment, de façon ponctuelle, pour éviter un confit aux conséquences fâcheuses. Mais risqué sur le long terme, car il engendre une charge de stress croissante et débouche souvent sur des ruminations : on revient alors mentalement et sans relâche sur l’épisode, nourrissant amertume et rancœur… et sentiment d’impuissance, voire de lâcheté.
Avec des conséquences potentiellement sérieuses pour la santé physique et mentale, puisque la suppression des émotions bloque l’expression extérieure du ressenti (vous vous retenez de crier et de gesticuler), mais pas l’activité de certaines zones du cerveau donnant naissance au ressenti lui-même, comme l’amygdale cérébrale (voir l’encadré ci-contre). Du coup, l’activité de l’axe du stress augmente, de même que le risque de souffrir d’anxiété généralisée, de toxicomanie, ou de dévalorisation de soi. En 2013, une étude de l’université de Rochester montrait ainsi que sur un échantillon de 800 personnes suivies sur douze ans, celles qui supprimaient le plus leurs émotions vivaient en moyenne moins longtemps que les autres, notamment à cause d’une plus forte incidence des cancers. La suppression des émotions modife aussi à terme le comportement… On devient moins sociable, plus sec et agressif, et on fnit par s’isoler, voire par être mis à l’écart par les autres. De façon générale, bloquer l’expression des émotions peut se retourner contre vous, mais empêche aussi ces dernières de remplir leur rôle social en communiquant votre état à ceux qui vous entourent. Certes, exploser de rage devant votre responsable serait très mauvais pour votre situation professionnelle, mais ne rien montrer ne lui permettra pas de se poser des questions sur son mode de management ni de prendre en compte vos besoins. Il va continuer à se comporter comme avant, sans même savoir que cela pose problème ; la situation est donc susceptible de s’éterniser, avec toujours plus de ruminations pour vous, et le risque de sortir un jour de vos gonds plus violemment.
Les émotions ont un rôle social important à jouer, que l’on observe dans les situations de détresse, de tristesse ou de deuil : une personne qui montre son chagrin dans ce type d’épreuves signale qu’elle a besoin de soutien, et en reçoit souvent – alors que celle qui réprime toute manifestation d’affect se trouve généralement isolée.
Pour ne pas avoir à ravaler leur colère indéfniment, certains individus préfèrent éviter
les situations à risque. Par exemple, en esquivant des sujets sensibles dans le couple, quand on connaît sa propre tendance à perdre ses nerfs lorsqu’on les aborde. Ou bien, en se faisant excuser pour des réunions de travail qui vous feront à coup sûr bouillonner intérieurement, avec le risque de « péter un câble ». Il peut s’agir de soirées auxquelles on décide de renoncer : « Il vaut mieux que je n’aille pas chez les Dupuis, je sais que je ne vais pas supporter son discours sur les étrangers et je vais lui sortir ses quatre vérités. » Mais là encore, la diffculté à gérer l’émotion est source de stress, ce qui se traduit par les mêmes effets négatifs à long terme que pour la suppression affective, sans compter les diffcultés pratiques qui en découlent souvent – il y a quand même des réunions auxquelles on ne peut pas couper. En outre, les conduites d’évitement à répétition présentent le risque fâcheux de dériver vers des phobies d’évitement ou des angoisses sociales, au
Pour garder son calme, plusieurs stratégies sont envisageables. Tout d’abord, la suppression émotionnelle (A) : elle consiste à ne rien montrer et à faire comme si tout allait bien. Visage impassible, calme apparent, on évite de craquer par un e ort de la volonté. Les études d’imagerie cérébrale montrent alors que notre cortex préfrontal entre en activité pour bloquer les manifestations extérieures de la colère, mais que l’amygdale impliquée dans la génération de l’émotion négative et l’insula responsable des ressentis intérieurs, notamment au niveau viscéral, voient leur activité

point de se tenir à l’écart de toute circonstance qui peut se révéler contrariante.
Pour toutes ces raisons, il semble vain, voire contreproductif, de vouloir bloquer la colère ou d’évacuer toutes les situations qui peuvent lui donner naissance. Si l’émotion prend forme, apprendre à la réguler est de loin la meilleure solution.
LA CLÉ : APPRENDRE À « RÉGULER »
SES ÉMOTIONS
Une bonne régulation émotionnelle est associée, selon les études de psychologie scientifque, à de meilleurs niveaux de bien-être subjectif et à une amélioration de la santé physique et mentale. Bien régulées, les émotions – notamment négatives comme la peur ou la colère – ne provoquent pas d’accumulation du stress sur la durée, ce qui préserve du développement de l’anxiété ou de la dépression. Mais en quoi consiste la régulation émotionnelle ?
Tout commence par une première étape : la prise de conscience. Condition indispensable pour pouvoir agir effcacement sur ses ressentis : savoir les repérer, les identifer et les nommer. Mais également noter la façon dont ils prennent forme et les circonstances au cours desquelles ils se manifestent. Un moyen valable d’y parvenir est de tenir un journal de bord où l’on pratiquera ce qu’on appelle l’« écriture expressive ». Sur le carnet, on va inscrire quotidiennement ce qu’on a vécu, à quel moment on a ressenti telle ou telle émotion, et ce que cela produit « à l’intérieur ». Si l’on souhaite se prémunir contre les accès de colère, et rester zen le plus souvent possible, on pourra ainsi répertorier les différentes situations de la journée où cette émotion s’est manifestée. Où était-ce, en présence de qui, en réponse à quels types de propos ou de problème ? Qu’ai-je éprouvé, ai-je réussi à l’exprimer ? Il s’agit d’apprendre petit à petit à identifer ces ressentis en se dotant d’un lot d’étiquettes qui
augmenter. On ne bouge pas, mais on bouillonne et on sou re intérieurement.
Deuxième possibilité : réévaluer son émotion (B). Il s’agit de considérer la situation problématique sous un angle di érent. Le cortex préfrontal s’active cette fois non pour bloquer l’expression de l’émotion (vous pouvez d’ailleurs avoir l’air énervé), mais pour relativiser la situation. L’activité de l’amygdale et celle de l’insula diminuent : on relâche la pression, le sentiment de colère diminue. Troisième option : la méditation de pleine conscience (C). À pratiquer régulièrement, pas seulement quand la colère

arrive ! On observe alors un phénomène analogue : une activation du cortex préfrontal et une réduction de l’activité de l’amygdale, de l’insula et d’une autre région impliquée dans le traitement des émotions, le gyrus parahippocampique. Les deuxième et troisième stratégies demandent plus de préparation au quotidien, mais évitent l’accumulation de stress et les conséquences délétères de la suppression émotionnelle pour la santé physique et mentale à long terme.

DOSSIER
OBJECTIF : GARDER SON CALME
leur seront accolées : « colère », « frustration », « irritation », « énervement », « révolte », ainsi que toutes les autres nuances indispensables pour en donner une description fdèle. Progressivement, il est question d’acquérir cette compétence de mettre des mots sur ce que l’on ressent, non pas seulement un mot, mais une gamme de termes précis, voire de petits schémas mentaux qui pourront relier une situation type, une personne, un lieu, une étiquette émotionnelle, et éventuellement un éventail de possibilités d’actions dont on pourra dans un second temps trier l’effcacité.
Quel est l’intérêt de ce travail ? Savoir comment et quand on réagit. Il est essentiel d’avoir une bonne connaissance des circonstances qui vont susciter en nous de la colère, de la frustration et de l’énervement, pour pouvoir anticiper ses propres réactions, et ce afn de ne pas être pris au dépourvu au moment crucial, et de prendre les mesures nécessaires. Envisageons l’exemple d’une réunion de travail où un salarié anticipe une situation de conflit. Depuis quelques semaines, il tient un journal de bord et sait ce qui est susceptible de se produire, car il a balisé la succession de ressentis qui risquent de lui « tomber dessus » à ce moment-là. Et il a prévu de mettre en œuvre une stratégie d’assertivité – qui repose sur la prise de parole pour exprimer son besoin d’être entendu – et le fait que certaines décisions prises par sa hiérarchie puissent le mettre dans une situation d’inconfort, voire de détresse. Alternativement, il a envisagé une stratégie de « distraction attentionnelle » par de la prise de notes, pour diriger l’attention ailleurs et laisser l’émotion retomber sans la bloquer entièrement. Au besoin, il a réfléchi à une manière d’exprimer son mécontentement de façon acceptable et relativement brève, sans que cela entraîne une trop longue digression dans la réunion. Anticiper, prévoir, avoir des scénarios de rechange, tout cela prend forme quand on s’est familiarisé avec ses propres ressentis et les différents déclencheurs qui les suscitent.
RÉÉVALUER SA COLÈRE
POUR LA FAIRE RETOMBER
À cela s’ajoute une dernière stratégie particulièrement effcace, étayée sur des décennies d’études en psychologie, qui consiste non pas seulement à anticiper l’arrivée de la colère, mais à changer de perspective sur cette dernière : en un mot, la réévaluer.
Selon un des spécialistes de la régulation des émotions, le psychologue James Gross, de l’université Stanford, la stratégie de réévaluation cognitive des émotions est associée à une
réduction des symptômes dépressifs et anxieux, à davantage d’émotions positives, d’optimisme et de bien-être, ainsi qu’à des relations sociales épanouissantes. Pour la psychologue américaine Carol Ryff, de l’université du Wisconsin, à Madison, cette stratégie s’accompagne en outre d’un sentiment d’autonomie, d’un développement personnel plus accompli et d’une meilleure acceptation de soi et des autres. Qu’est-ce que la réévaluation cognitive des émotions ? Il s’agit d’une démarche mentale par laquelle on réinterprète une situation et les réactions affectives qu’elle a déclenchées. Imaginons : vous venez de passer un entretien d’embauche pour un poste qui vous intéresse. Vous recevez une lettre vous informant que
Lorsque nous nous mettons en colère, c’est généralement que nous nous sentons vulnérables et en situation de perte de contrôle. Face à ce ressenti, renforcer son sentiment d’assurance et de maîtrise, notamment en consolidant son estime de soi, représente une voie d’action intéressante. Plusieurs études, menées aussi bien aux États-Unis qu’au Royaume-Uni ou même en Malaisie, ont ainsi révélé que, statistiquement, les sentiments de colère et les comportements d’agression sont liés soit à une faible estime de soi, soit à une estime de soi instable. Rehausser son estime de soi peut être un travail de longue haleine, mais par rapport aux situations de colère incontrôlée, il peut être judicieux d’opérer quelques ajustements ciblés. Un exemple est celui d’un parent dont les nerfs craquent quand son ado laisse entendre qu’il n’a pas de leçons à lui donner, parce qu’il n’a pas particulièrement bien réussi professionnellement à ses yeux. Voilà un thème sensible où il vaut mieux avoir fait le point préalablement sur ses réussites personnelles, et parvenir à porter un regard positif sur soi-même, pour ne pas se laisser submerger par ses émotions et cette fameuse colère qui surgit quand on se sent rabaissé. En parler avec son conjoint, se rassurer auprès de ses collègues, prendre conscience qu’on est compétent dans son domaine, tout cela peut largement contribuer à éviter le conflit et à laisser glisser les remarques sans y donner prise. Il y a mille façons de se sentir valable, qu’il s’agisse d’e ectuer une réparation dans la maison, d’apporter de l’aide à un ami, de cultiver une compétence sportive ou artistique ou de se montrer utile au sein d’une association. Au moment où votre enfant remettra en cause vos capacités, ces réussites joueront un rôle protecteur et vous aideront à rester calme. Mais il ne faut pas s’y prendre au dernier moment.
vous n’avez pas été sélectionné, tout en vous livrant un certain nombre de raisons motivant ce refus. Votre première réaction est la rage. Vous êtes furieux, vous en voulez à ces incompétents qui vous ont barré l’accès à ce poste que vous désiriez tant et qui était fait pour vous. Pourtant, si vous le décidez, vous pouvez également enclencher une démarche de réévaluation cognitive de votre colère. Premièrement, vous pouvez vous demander pourquoi vous êtes si remonté. Peutêtre parce que vous êtes convaincu que cet échec est véritablement dramatique et qu’aucun autre poste aussi attirant ne se représentera à vous. Ou parce que vous avez l’impression que votre CV n’était pas assez bon, ce qui ébranle votre confance en vous. Ce court examen a une vertu : il montre que ce qui provoque la colère, ce n’est pas le refus, mais l’interprétation du refus. Or il est possible d’en élaborer, justement, une interprétation différente. Ainsi, votre nom était en haut de la liste pour l’admission au poste, ce qui est en soi une réussite. Par ailleurs, on peut toujours trouver un CV meilleur que le sien, c’est inévitable et cela ne remet pas en cause votre valeur sur le marché du travail. Troisièmement, vous avez encore d’autres rendez-vous pour des entretiens, et rien ne vous permet d’affrmer défnitivement qu’aucune autre opportunité ne sera aussi intéressante que cela. Enfn, vous avez noté certains aspects de votre performance pendant l’entretien qui étaient clairement réussis et d’autres non, ce qui vous permettra de progresser. Au terme de ce rapide examen, en changeant de point de vue sur ce qui a déclenché l’émotion, vous avez modifé l’émotion elle-même.
temps chez les individus qui décident de la mettre en œuvre de plus en plus souvent dans leur vie. C’est un domaine dans lequel les marges de progression sont importantes.
Autre bonne nouvelle : les bénéfces sont substantiels. Les personnes les plus « réévaluatrices » sont statistiquement, selon les études menées sur des cohortes de volontaires, en meilleure santé que les faibles réévaluatrices ; elles ont globalement une meilleure qualité de vie, sont mieux perçues par les autres, ont plus d’amis. C’est une stratégie facile à travailler, seul ou avec un thérapeute qui va vous amener à repenser aux événements, à trouver des mots pour les évoquer et les considérer sous un autre angle, à tenter de mettre sur le papier des choses qui vous préoccupent ou qui vous mettent en colère, et à en parler à autrui.
Notre cerveau est plastique, et la façon dont les émotions prennent forme, se développent dans le temps et ont un impact sur notre vie intérieure et nos relations sociales peut être considérablement remaniée par notre positionnement cognitif visà-vis d’elles. Une approche particulièrement intéressante de ce point de vue est apportée par la méditation de pleine conscience, qui va associer une meilleure prise de conscience de nos affects (ce qui aide à se familiariser avec eux, à les nommer et les réguler) et une capacité de distanciation qui limite leur ampleur. Des études ont ainsi montré qu’à mesure que l’on accumule des heures de pratique, les zones cérébrales associées à la génération d’émotions négatives, comme l’amygdale, s’enflamment moins violemment, tandis que les zones régulatrices de notre cerveau, comme le cortex préfrontal, entrent en jeu. Et plus on s’entraîne, moins cet effort est coûteux cognitivement, et s’enclenche alors facilement.
K. D. Vohs et R. F. Baumeister (éd.), Handbook of Self-Regulation. Research, Theory, and Applications, Taylor & Francis, 2017 © EladoraShutterstock ; source M. H. Kerni et al. , Stability and level of self-esteem as predictors of anger arousal and hostility, J. Pers. Soc. Psychol. 1989. S. Amad et al. , Self-Esteem, narcissism, and aggression : different types of self-esteem predict different types of aggression, J. Interps. Violence , 2021.
Cela prémunit-il entièrement contre les risques de « disjoncter » dans des situations « sur le vif », en temps réel ? La réponse est oui, en partie. Car c’est en répétant cet exercice plusieurs fois, au fl des expériences émotionnelles, qu’il se fait de plus en plus naturel. Une automatisation qui va être décisive pour que, en situation « chaude », la réévaluation cognitive puisse se faire en direct. En effet, lorsque nous sommes submergés par la fureur, nous disposons de peu de ressources cognitives pour déployer un effort conscient comme celui décrit plus haut. Si la stratégie est automatisée, on pourra l’enclencher, mais si elle est trop coûteuse en ressources cognitives, ce sera impossible. C’est pourquoi il faut solliciter cette aptitude le plus souvent possible, comme un muscle, afn que ce dernier puisse se contracter spontanément en situation de confit. De fait, les travaux de psychologues comme Brett Ford, à l’université de Toronto, ont montré que la capacité de réévaluation émotionnelle se développe avec le
Reste, nonobstant, que nul n’est taillé dans le marbre et que, malgré toutes ces précautions, la possibilité n’est jamais exclue que l’on perde le contrôle chez soi, en public, au travail ou tout simplement en s’énervant contre une étagère qu’on n’arrive pas à fxer au mur. Là encore, les dégâts peuvent être limités par une attitude appropriée. À condition d’avoir développé une bonne capacité de prise de conscience de ses affects, chacun est à même de constater qu’il n’est plus en état de discuter, et de prendre la décision de sortir respirer pendant cinq minutes. C’est généralement suffsant pour que le pic émotionnel soit dépassé et que l’on soit de nouveau capable d’interagir à tête reposée… £
B. Q. Ford et al., Understanding reappraisal as a multicomponent process : The psychological health benefits of attempting to use reappraisal depend on reappraisal success, Emotion, 2017
B. P. Chapman et al., Emotion suppression and mortality risk over a 12-year follow-up, Journal of Psychosomatic Research, 2013
J. W. Pennebaker, Expressive writing in psychological science, Perspectives on Psychological Science, 2018.
p. 58 L’enfance du crime p. 64 Raison et déraison p. 68 Foot : gare aux têtes ! p. 74 Apprenons-nous vraiment de nos erreurs ?
Nicolas Gauvrit, enseignant-chercheur en sciences cognitives à l’université de Lille, et Hayet Zeghiche, journaliste.
Plus de trois ans après l’épidémie de Covid-19, Didier Raoult fait encore régulièrement parler de lui en France et à l’étranger. Récemment, le très médiatique professeur marseillais s’est vu débouté par le tribunal correctionnel de Marseille après avoir attaqué pour diffamation son homologue du Centre hospitalier universitaire de Grenoble, Jean-Paul Stahl. En effet, l’ancien directeur de l’institut hospitalouniversitaire Méditerranée Infection se serait distingué par le nombre d’études scientifques frauduleuses sur l’hydroxychloroquine publiées lors de la pandémie. Dans un article paru le 7 mars, la prestigieuse revue Science allait même jusqu’à parler d’imposture. Plus encore, il avait fait part de positions très controversées sur d’autres sujets, comme le réchauffement climatique ou la théorie de l’évolution.
Le portrait dressé dans Science détonne d’autant plus que Didier Raoult a reçu plusieurs prix scientifques prestigieux – Grand Prix 2010 de l’Inserm et Prix scientifque 2015 de la fondation Louis D (une distinction scientifque décernée par l’institut de France). Et il reste l’un des chercheurs les plus référencés dans son domaine, avec plus
Un mal étrange frappe les lauréats de la prestigieuse distinction : certains se croient infaillibles, disent n’importe quoi et émettent des théories farfelues en sortant de leur champ de compétence. Comment expliquer une telle panne de l’intelligence ?
£ Le syndrome du prix Nobel, encore appelé nobélite, désigne la tendance de certains lauréats du prix à penser tout savoir sur tout et à proposer des thèses aberrantes sur des sujets qu’ils ne connaissent pas.
£ Une cause probable : les qualités cognitives dont ils jouissent sont aussi des fragilités face au succès trop brusque lorsqu’elles sont mêlées à une personnalité narcissique.
£ Ainsi, l’intelligence ne garantit pas l’esprit critique… Et la créativité, si précieuse pour innover, peut virer au délire si le chercheur couronné oublie le principe essentiel d’humilité intellectuelle.
de 230 000 citations scientifques. Il est donc plutôt troublant de constater qu’en dépit d’un rayonnement international acquis pour ses travaux en microbiologie, il n’hésite pas à prendre le consensus scientifque à rebrousse-poil.
DIDIER RAOULT, PSEUDO-EXPERT DU COVID-19
Pourtant, le professeur est loin d’être un cas isolé. De nombreuses autres personnalités scientifques ont également fait preuve d’une déroutante irrationalité, certaines ayant même une carrière exceptionnelle avec un – voire deux –prix Nobel. Ce phénomène est connu sous le nom de « syndrome du prix Nobel » ou « nobélite » : un nombre surprenant de lauréats du prix Nobel dans le domaine des sciences deviennent auteurs de déclarations extrêmement douteuses. Les exemples ne manquent pas (voir l’encadré page 54). Des très contestés Luc Montagnier et Michael Levitt, qui ont secoué l’opinion publique avec leurs affrmations complotistes dans le documentaire de Pierre Barnérias, Hold-up, retour sur un chaos (2020), en passant par Linus Pauling, pape contesté de la vitamine C, et Kary

Lauréat du prix Nobel de médecine en 2008 pour la découverte du virus du sida, Luc Montagnier déclarera plus tard que les vaccins peuvent causer l’autisme. Sans aucune preuve.
Mullis, qui a déclaré avoir reçu la visite d’aliens ayant pris la forme de ratons laveurs, ou encore Richard Smalley, connu pour son fervent militantisme créationniste… Tous ont en commun cette improbable particularité de marier accomplissements scientifiques et postures pseudoscientifques.
Comment des savants internationalement reconnus pour leur contribution exceptionnelle dans des domaines très pointus se laissent-ils séduire par des idées scientifquement discutables ? En fait, les qualités nécessaires pour atteindre cette consécration scientifque sont en même temps le talon d’Achille de ces chercheurs hors norme, et peuvent les desservir quand la renommée les atteint. Le psychologue américain Joseph Renzulli, spécialiste du haut potentiel intellectuel, cite trois caractéristiques indispensables pour produire des réalisations intellectuelles extraordinaires : l’intelligence, la créativité et l’engagement dans la tâche qu’on s’est fxée. En outre, une grande

LINUS PAULING
KARY MULLIS


RICHARD SMALLEY
LUC MONTAGNIER


MICHAEL LEVITT
JOHN F. CLAUSER

1954 Chimie Chimie quantique, structures des molécules.
1993 Chimie Réaction en chaîne de la polymérase (PCR).
ouverture d’esprit et une bonne dose de narcissisme sont des avantages certains pour réussir à ce niveau. Or ces qualités ne garantissent pas que, face aux honneurs et à la gloire qui font suite à la consécration, le lauréat conserve un regard critique sur ses propres idées. Bien au contraire, certaines d’entre elles peuvent même se retourner contre lui. Il risque alors de basculer dans un mélange de suffsance et de relâchement intellectuel l’amenant à dire n’importe quoi.
INTELLIGENTS… MAIS IRRATIONNELS ?
Tout d’abord, être intelligent ne garantit pas que l’on possède un esprit critique capable de résister aux biais cognitifs, de déjouer les tours des escrocs, et de ne pas sombrer dans des croyances baroques. L’esprit critique est circonscrit à une thématique précise et chaque domaine de la connaissance dispose de ses propres règles : une preuve en mathématique a peu en commun avec une preuve en médecine.
Il a a irmé, entre autres, que des mégadoses de vitamine C étaient e icaces contre la schizophrénie, sans qu’aucune étude scientifique n’ait jamais pu corroborer ses dires.
Connu pour son usage intensif de LSD, Karry Mullis a revendiqué des opinions polémiques sur le sida, les extraterrestres, les projections astrales… Il s’est également fait remarquer par son adhésion à diverses théories du complot et à des pseudosciences, comme l’astrologie.
1996 Chimie Découverte des fullerènes, troisième forme élémentaire du carbone (avec le graphite et le diamant).
2008 Médecine Découverte du virus du sida.
Il prétendait qu’après avoir lu Origines de la vie, de Fazale Rana et Hugh Ross, et avec sa formation en chimie et en physique, il était clair que l’évolution biologique n’avait pas pu se produire.
Il a a irmé que la plupart des maladies neurologiques proviennent d’ondes électromagnétiques émises par l’ADN viral ou bactérien dans des solutions aqueuses, que les vaccins causent l’autisme et que l’autisme peut être traité avec succès à l’aide d’antibiotiques.
2013 Chimie Modélisation multiéchelle des systèmes chimiques complexes.
Il est principalement connu pour ses déclarations pseudoscientifiques sur le coronavirus.
2022 Physique Mécanique quantique. En 2023, il rejoint la direction de la « CO2 coalition », un groupe climatosceptique.
Ainsi, un chimiste de talent n’est pas forcément capable d’évaluer de façon pertinente un raisonnement en histoire ou même en physique. Dès lors, tout spécialiste, aussi brillant soit-il, qui s’aventure hors de son champ risque de devenir fumeux en toute bonne foi. Par ailleurs, il y a une différence entre la capacité de raisonner et la propension à le faire ! Une grande intelligence fournit certes les outils indispensables à un raisonnement rigoureux, mais elle n’oblige personne à devenir rationnel ! On peut savoir faire du vélo et prendre sa voiture. Et l’on peut avoir toutes les compétences nécessaires pour évaluer un énoncé… et ne pas les utiliser.
La créativité, également indispensable pour viser des accomplissements dignes du prix Nobel, peut aussi prendre des formes plus douteuses. Une imagination fertile permet certes d’établir de nombreux liens entre des idées distantes, fournissant un matériel riche pour innover, mais encore faut-il opérer un tri parmi ce matériau hétéroclite. Par exemple, remarquer que certains fruits ont la forme d’un organe, telle la noix semblant un cerveau, c’est très bien. En tirer l’idée que les noix pourraient avoir des effets protecteurs sur le cerveau, pourquoi pas… Toutefois, « faire le tri » doit conduire à rejeter cette intuition tant qu’on n’a pas de preuves de cette association un peu tirée par les cheveux. La créativité sans fltre est une pensée qui part dans tous les sens et devient vite irrationnelle.
On voit dès lors le danger qui peut guetter les chercheurs très imaginatifs ! Dans le cas où la profusion sans frein de leurs associations libres ne serait pas rigoureusement épurée, le risque est de produire une pensée déconnectée de la réalité, telle qu’on la retrouve dans plusieurs pathologies mentales comme le trouble de la personnalité schizotypique, notamment caractérisé par des comportements et des idées bizarres ou excentriques.
Troisième caractéristique cruciale : la persévérance. C’est la capacité à fournir un effort intellectuel puissant et prolongé. On ne passera généralement pas vingt ans de sa vie à comparer des modèles cosmologiques si l’on n’a pas, outre la force de travail, la motivation nécessaire. Cette dernière peut être intrinsèque, liée au plaisir de fournir un effort intellectuel tourné vers des recherches novatrices. Elle peut aussi être « extrinsèque », et découler cette fois d’un besoin de médiatisation, d’une ambition débordante ou du brûlant désir d’obtenir des prix internationaux. Dans ce dernier cas, quand arrive le Nobel, cette soif de gloire peut complètement faire perdre le contact avec la pratique scrupuleuse de la science.
Les qualités nécessaires pour atteindre la consécration scientifique sont en même temps le talon d’Achille de ces chercheurs hors norme et peuvent les desservir quand ils rencontrent le succès.
Selon les chercheurs polonais Izabela Lebuda et Maciej Karwowski, certains traits de personnalité sont particulièrement importants pour réussir scientifquement au niveau d’un prix Nobel. Le plus important étant l’« ouverture », à savoir un appétit pour la nouveauté, une soif de connaître et d’expérimenter des choses inédites. La curiosité est un moteur de l’engagement dans la tâche qui se marie fort bien avec la créativité. Il en a fallu une certaine dose pour imaginer sérieusement que la lumière était à la fois une onde et un fux de particules – ou, en psychologie, qu’une image (subliminale) présentée de façon si brève que personne ne la perçoit consciemment ait malgré tout un effet mesurable sur nos comportements.
OUVERTURE D’ESPRIT…
OU THÉORIES ABRACADABRANTES ?
Mais, comme dans le cas de la créativité, cette capacité doit s’accompagner de garde-fous. Que je puisse imaginer l’existence de la télépathie est une chose, mais que j’y croie dur comme fer sur la seule base de mon intuition m’entraîne sur un terrain plus hasardeux. L’ouverture d’esprit est une chose, sa porosité à n’importe quelle sottise en est une autre. Et si les garde-fous se relâchent lorsque vous êtes adulé par les médias du monde entier, les dégâts peuvent être considérables. Enfn, on ne devient pas lauréat du prix Nobel par ses seules réalisations scientifques, ses qualités humaines et cérébrales ; il s’agit aussi de savoir (sur)vendre son talent, s’attribuer
des découvertes qui sont en réalité communes et entretenir un réseau de collègues admiratifs, fdèles et bien placés. Une grande ambition, une estime de soi élevée pour convaincre autrui de son niveau exceptionnel et pour se lancer dans des projets immenses et diffciles, une indifférence relative vis-à-vis de son prochain, une tendance à utiliser les autres (ses collaborateurs, ses étudiants…) à son propre avantage sont, hélas, autant d’atouts pour décrocher le graal. En un mot : une personnalité narcissique favorise l’obtention de grands prix scientifques. Or une telle personnalité – on le conçoit aisément – va à l’encontre de l’humilité intellectuelle indissociable de l’esprit critique. Quand les honneurs se mettent à pleuvoir après l’annonce du prix, ce narcissisme va alors se répandre en apparitions médiatiques incessantes qui lui feront vite oublier le sens de la mesure et de la rigueur.
D’une certaine façon, le prix agit comme un détonateur chez certaines de ces fgures. Sans le crible de la pensée analytique, la créativité débridée du lauréat peut déboucher sur des idées délirantes. S’il est trop sûr de lui, il risque d’accorder une fabilité excessive à ses intuitions et de ne plus trier ses nombreuses idées – alors qu’elles sont pour la plupart à rejeter. Son ouverture d’esprit peut le conduire à envisager sans diffculté des hypothèses contraires au bon sens et à la science contemporaine. Dans les cas fort rares où de telles considérations seraient conformes à la réalité, malgré leur
Selon le psychologue américain
Robert Sternberg, 5 facteurs concourraient à faire basculer un individu dans des croyances étranges et infondées. Le succès lié à l’attribution du prix Nobel va presque mécaniquement renforcer ces 5 facteurs, avec le risque de faire perdre au lauréat le sens de la mesure.
apparente bizarrerie, il sera un pionnier. Mais s’il est pris de folie des grandeurs et se sent invulnérable aux biais, il sera propulsé dans le monde du charlatanisme, du mysticisme ou, comme on le dit de plus en plus, du « n’importe quoi » – bref, du bullshit
De fait, le prestige que confère le prix Nobel est tel que les lauréats se trouvent souvent propulsés brutalement dans un autre univers, à plusieurs égards. D’abord, les médias se mettent soudainement à les interroger à propos de tout et de n’importe quoi, leur demandant leur avis sur des sujets qui débordent largement de leur champ de compétences. Tel physicien va alors répondre à une interview sur la notion d’intelligence – sans avoir la moindre compétence en psychologie. Tel chimiste sera considéré comme un critique d’art expert, du jour au lendemain, au prétexte qu’il a été admis au panthéon des grands cerveaux. Encensés par tous, perçus comme des génies, seuls les caractères les plus solides – à l’humilité fermement ancrée – seront capables de résister à l’image d’omnipotence et d’omniscience que tout le monde leur tend. Il leur est alors diffcile de résister à l’aura et à l’omniprésence médiatique qu’ils pensent souvent avoir méritées, poussés en cela par un fond narcissique qui les a hissés jusqu’au prix. Dès lors, beaucoup s’exhibent, donnent leur avis sur tout… Ce qui ouvre la voie
Illusion d’omnipotence
Idée selon laquelle rien n’est trop di icile pour un cerveau brillant
Optimisme excessif quant à ses propres capacités
Illusion d’invulnérabilité
Pousse à croire qu’on ne peut pas se tromper
Conviction d’être à l’abri des biais cognitifs ou des erreurs de jugement
Égocentrisme
Conduit à minimiser l’importance des autres et de leurs idées
Illusion d’omniscience
Fait qu’on se considère légitime pour s’exprimer sur n’importe quel sujet
à la création d’un pseudo-expert d’un type particulier : celui qui, spécialiste d’un domaine, se perd dans un autre avec l’assurance ridicule des néophytes affétés.
Le chercheur américain Richard Hamming, des laboratoires Bell, décrivait, en 1986, ce qu’il advenait parfois des lauréats du prix Nobel. Il évoquait notamment une pluie de demandes de collaborations et de propositions de fnancement qui, paradoxalement, les coupe de leur métier de chercheur. Par manque de temps, les nobélisés se trouvent souvent contraints de réduire drastiquement leur rythme de travail, tout en répondant à une attente d’excellence de la part du public, ce qui les pousse à ne plus examiner que les « grandes questions » – entendez, les plus difficiles –, le reste étant considéré comme incompatible avec leur hauteur de vues.
Pour certains, mus par la soif de reconnaissance et le désir de rester dans le brouhaha admiratif des médias, c’est la porte ouverte à un effet pervers. Manque de temps pour poursuivre de vraies recherches, course à la surenchère pour faire le buzz, besoin d’exposition permanente : tout cela fnit par éloigner le lauréat des laboratoires pour le transformer en personnalité médiatique avide de temps de parole. À l’arrivée : discours péremptoires et affrmation décomplexée d’opinions peu fondées portant sur n’importe quel sujet à la mode. Le tableau est quelquefois désastreux. Le prestige du prix pousse certains récipiendaires à s’aventurer en terre de savoirs inconnus d’eux, et les plonge dans un monde d’adulation perturbant. Pour des personnalités déjà imbues d’elles-mêmes, un tel traitement, en amplifant le narcissisme, a vite fait de virer à la folie des grandeurs.
«
Le psychologue américain Robert Sternberg a proposé en 2004 une liste de cinq « péchés intellectuels » qui conduiraient ainsi à l’irrationnel, aux croyances étranges et infondées (voir l’encadré page ci-contre). Ces cinq péchés seraient un optimisme excessif quant à ses propres capacités, qui conduit à croire qu’on ne peut se tromper, l’égocentrisme, qui fait minimiser l’importance des autres et de leurs idées, et une triple illusion d’omniscience (qui justife qu’on s’exprime sur n’importe quel sujet), d’omnipotence (qui laisse croire que tout est « à portée de cervelle », même les problèmes les plus ardus de la science) et d’invulnérabilité (où l’on se pense à l’abri des biais cognitifs et des erreurs de jugement).
Ces travaux sont fondés sur l’analyse de nombreux cas historiques et sont convaincants
L’intelligence ne garantit pas l’esprit critique… Et la créativité, si précieuse pour innover, peut virer au délire si le chercheur couronné oublie le principe essentiel d’humilité intellectuelle.
même s’ils ne s’accompagnent pas de mesures statistiques établissant clairement une corrélation entre ces cinq facteurs et la bascule vers l’irrationnel. Chez les Prix Nobel, on conçoit aisément comment la combinaison de leurs prédispositions – créativité, intuition, haute estime de soi… – et des effets du prix – encensement, demandes chronophages et pression à s’exprimer hors de son champ d’expertise – est de nature à favoriser l’apparition de ces cinq malheureux traits et à augmenter la probabilité de sombrer dans la pseudo-expertise, l’adhésion à des calembredaines et la défense d’idées bizarres.
Que tirer de tout cela ? Si aucune étude scientifque ne démontre que les lauréats du prix Nobel sont sujets, plus que les autres personnalités internationalement reconnues, aux idées bizarres et autres dérapages cognitifs, il n’en reste pas moins troublant que de tels esprits rompus à l’exercice de la raison puissent être séduits par des postures de pseudo-experts ou devenir adeptes de théories farfelues en tout genre.
L’attente du public par rapport à ces symboles d’excellence et de savoir est telle qu’une « tolérance zéro bullshit » est de mise : ils ne devraient pas pouvoir se permettre de répandre des idées fausses. Pour atteindre ce but, on serait en droit de revendiquer que les institutions de recherche et les médias appliquent des règles déontologiques strictes. À défaut d’un cadre légal effectif, l’exemple des groupes de chercheurs « lanceurs d’alerte » célébrés par Science et ayant permis de faire tomber Didier Raoult, reste encourageant. £
Bibliographie
S. Dieguez et N. Gauvrit, L’Expertise sans peine, Éliott, 2023. I. Lebuda et M. Karwowski, Personality of Nobel prize laureates : Di erences across domains and relationship to public recognition, Psychology of Aesthetics, Creativity, and the Arts, 2021. S. O. Lilienfeld et al., Nobelists gone wild : Case studies in the domain specificity of critical thinking, Critical Thinking in Psychology, 2020 C. Rominger et al., Allusive thinking (remote associations) and auditory topdown inhibition skills di erentially predict creativity and positive schizotypy, Cognitive Neuropsychiatry, 2017 R. J. Sternberg, Why smart people can be so foolish, European Psychologist, 2004

Professeur de psychologie au collège Saint-Michel et collaborateur scientifique à l’université de Fribourg, en Suisse.
Un mantra du développement personnel dit : « On n’apprend bien que de ses erreurs. » Résultat : certains gourous invitent à célébrer les ratés et les échecs ! Sans penser que l’objectif est tout de même d’arrêter de se tromper…
«C’est fantastique, tu t’es trompé ! » J’ai découvert cette phrase en surimpression d’une belle image censée être inspirante sur des sites vantant les vertus de l’erreur. L’idée, intéressante au demeurant, est que l’on apprend beaucoup de nos échecs. Il faudrait donc féliciter les enfants et les collègues qui se trompent plutôt que de les blâmer. Certaines entreprises, à la pointe des dernières modes managériales, ont même instauré des failure parties, des rencontres où l’on fête les erreurs commises, puisque cela permet aux autres de les éviter à l’avenir (« Applaudissons Paul, qui a fait une fausse manœuvre coûtant plus de 50 000 euros à l’entreprise. Grâce à lui, nous l’avons identifée et avons pu corriger la procédure
problématique. Bravo ! Nous ne pourrons cependant pas verser de salaires ce mois-ci, faute de trésorerie. »). Faut-il vraiment célébrer les erreurs et les échecs, comme le soutiennent certains coachs en entreprise ?
Au fond, personne n’est dupe. Même si l’on instaure une politique de tolérance aux erreurs, tout le monde sait qu’il est préférable de ne pas se tromper. Avoir juste vaut mieux que d’avoir faux. Prenez le cas de l’école. Même si l’on valorise les erreurs commises par les élèves comme source d’apprentissage, le but est tout de même de les repérer pour faire en sorte qu’elles se reproduisent le moins possible, voire pas du tout, surtout au moment des évaluations et des examens. La bonne erreur, c’est celle que l’on ne fait plus. Dans le milieu
professionnel, c’est également une évidence : qui voudrait se faire opérer par un chirurgien qui apprend beaucoup de ses multiples erreurs ? Et qui voudrait monter dans un avion piloté par un commandant qui voit une erreur au décollage comme une bonne nouvelle et un moyen de devenir meilleur pilote ?
L’ENCOURAGEMENT AU RATAGE
D’un strict point de vue psychologique et neurologique, il est aberrant de célébrer les erreurs. Il y a plus d’un siècle, le psychologue américain Edward Thorndike identifa la « loi de l’effet », dont l’énoncé est clair : tout comportement qui produit un effet positif ou agréable voit sa probabilité de se reproduire augmenter. C’est la base du conditionnement opérant, étudié

l’avenir, d’après un mécanisme inscrit au plus profond des circuits neuronaux. L’aversion à l’erreur est un héritage évolutif qui doit beaucoup à un ensemble de connexions nerveuses et endocrines dans notre corps, appelé « axe du stress ». Une place de choix y est occupée par l’amygdale cérébrale, un véritable centre de la peur et des émotions négatives. Pendant des centaines de milliers d’années, si vous manquiez votre cible à la chasse, vous rentriez le ventre vide. Et encore, si vous en reveniez, car la cible en question pouvait aussi être un dangereux prédateur.
Tout n’est pourtant pas à jeter dans cette idée de célébrer nos erreurs. Car si rentrer de la chasse bredouille est incontestablement désagréable, apprendre en profondeur par son successeur Burrhus Skinner, qui devint un fondement d’un vaste courant en psychologie, le béhaviorisme. Qu’est-ce que cela signife pour le sujet qui nous occupe ? Eh bien, glorifer les erreurs, c’est donc les encourager. Sans même parler de l’effet cobra, dont le nom est tiré de l’anecdote portant sur la décision d’un gouverneur de Bombay de payer les peaux de serpent qu’on lui amènerait pour inciter les habitants à chasser les cobras qui infestaient la ville. Résultat : des petits malins ont commencé à élever ces serpents pour se faire de l’argent. Si l’on célèbre les bévues, pourquoi ne pas en commettre volontairement pour connaître son heure de gloire ?
L’erreur et l’échec doivent causer un désagrément afn qu’ils soient évités à
de nos ratés permet effectivement de s’améliorer. En d’autres termes, les échecs ont bien une vertu pédagogique. Mais pour cela, encore faut-il qu’ils soient portés à la connaissance de tous. Les recherches d’Amy Edmondson, professeuse à la Harvard Business School et spécialiste reconnue du traitement de l’erreur (cela fait mieux que « spécialiste de l’erreur ») montrent que si l’on ne réprimande pas les employés qui ont commis des bourdes, on crée un environnement où la sécurité psychologique sera de mise. Les collaborateurs n’auront pas peur d’être critiqués en cas d’erreur et seront plus prompts à les partager avec les autres, ce qui per mettra à tous de ne pas les commettre à leur tour. Bénéfce garanti pour l’entreprise.
ÉCLAIRAGES L’envers du développement personnel
APPRENONS-NOUS VRAIMENT DE NOS ERREURS ?
Ce que l’on célèbre alors, ce n’est pas l’erreur en tant que telle. C’est le fait de la partager ouvertement, afn que la leçon soit proftable à chacun. Alors, apprendrait-on davantage des erreurs des autres que des siennes propres ? C’est ce que semble effectivement révéler une série d’études menées par Lauren Eskreis-Winkler et Ayelet Fishbach, toutes deux professeuses à l’université de Chicago. Les participants de ces études sont confrontés à des symboles inconnus dont ils doivent deviner la signifcation. Par exemple, lequel parmi ces hiéroglyphes représente-t-il un animal : ou ? Certains sujets reçoivent des retours des instructeurs leur indiquant que leur réponse est juste, alors que d’autres obtiennent des retours d’erreur. Dans les deux cas, tout le monde découvre la signifcation correcte des symboles présentés.
C’est dans la suite de l’expérience que la différence émerge. Les symboles maintenant connus des participants réapparaissent parmi d’autres nouveaux hiéroglyphes. Les volontaires ont-ils appris de la phase précédente ? Il se trouve que ceux dont on a souligné la réussite obtiennent systématiquement de meilleurs résultats que ceux à qui on a spécifé leurs erreurs. Un résultat invariable même lorsqu’on change les conditions expérimentales, par exemple en promettant de l’argent pour chaque bonne réponse. Il semble bien que l’on apprend mieux, en tout cas que l’on mémorise mieux, de nos bonnes que de nos mauvaises réponses. Pourquoi une telle asymétrie, puisque les réponses correctes sont données à chacun ?
L’hypothèse des chercheuses s’est portée sur un phénomène connu sous le terme « menace de l’ego ». Les sujets à qui on signale leur erreur voient leur estime de soi vaciller : une part de leurs ressources cognitives est alors consacrée
D’un strict point de vue psychologique et neurologique, il est aberrant de célébrer les erreurs.
à protéger leur image personnelle, à se justifer, à trouver des raisons… Résultat : ils se déconcentrent et n’apprennent pas bien. Pour le vérifer, une dernière phase de l’étude a placé les participants en position d’observateurs : ils voyaient de tierces personnes recevoir les signaux de réussite ou d’erreur. Cette fois-ci, ils apprenaient de manière indifférenciée, aussi bien des uns comme des autres. Lorsque ce n’est pas nous qui commettons les erreurs, mais d’autres personnes, et que notre estime de soi n’est donc pas menacée, nous apprenons de manière effcace – on parle d’« apprentissage vicariant » – aussi bien des retours positifs que négatifs !
Valorisons donc le courage de parler ouvertement des erreurs et des échecs en instaurant un climat de sécurité psychologique, que ce soit dans la famille, à l’école ou au sein de l’entreprise. À cette condition, tout le monde pourra profter de ces enseignements sans croire que l’échec est désirable. £
Bibliographie
A. C. Edmondson, Right Kind of Wrong : The Science of Failing Well, Atria Books, 2023.
A. Castagnetti et R. Schmacker, Protecting the ego : Motivated information selection and updating, European Economic Review, 2022.
L. Eskreis-Winkler et A. Fishbach, Not learning from failure — the greatest failure of all, Psychological Science, 2019.












J’émets un chèque à l’ordre de Pour la Science du montant total de la commande. J’adresse le bulletin et mon chèque par courrier postal à l’adresse suivante :
Abonn’escient – TBS Group Service abonnement Groupe Pour la Science 20 rue Rouget de Lisle - 92130 Issy les Moulineaux
COMMANDEZ PLUS SIMPLEMENT !
En vous rendant sur notre site internet vous pourrez :
● Retrouver toute notre collection
● Vérifier la disponibilité des anciens numéros
● Acheter les numéros en version numérique (4,49 €)
● E ectuer un paiement en ligne
Pour cela, scannez le QR code ci-contre ou rendez-vous sur boutique.groupepourlascience.fr


Une question ? Contactez notre service clients à l'adresse : serviceclients@groupepourlascience.fr



PSYCHIATRIE
Schizophrénie et génétique
Boris Chaumette
Humensciences, 2024, 216 pages, 18 €
Avec plus de 20 millions de personnes touchées dans le monde, la schizophrénie est l’une des pathologies mentales qui suscitent le plus d’inquiétudes, d’idées reçues et de stigmatisation. Elle n’entraîne pas un dédoublement de la personnalité, comme on le croit souvent, mais ses symptômes n’en sont pas moins spectaculaires : idées délirantes, hallucinations, discours incohérent… D’où vient cette maladie ? Le psychiatre et chercheur Boris Chaumette, l’un des meilleurs spécialistes français de la question, explique ici son ancrage génétique. Son ouvrage est d’abord l’histoire d’une aventure scientifique qui n’a pas fini de nous surprendre. Il relate ainsi comment les chercheurs ont poursuivi de multiples pistes, fait parfois fausse route, pour finalement aboutir à des connaissances éclairantes sur la genèse de ce trouble. On savait qu’il était hétérogène, avec des combinaisons variées de symptômes, on découvre ici que les mécanismes le sont également : les variants génétiques détectés chez les patients perturbent par exemple le fonctionnement des synapses ou l’expression d’autres gènes. Mais, dans tous les cas, la schizophrénie n’a jamais une origine purement psychologique : « Ses causes sont résolument organiques, explique l’auteur. Cette nouvelle conception ouvre un espace fabuleux à la déstigmatisation, faisant de ce trouble incompris une maladie comme les autres. » Au passage, Boris Chaumette tord le cou à une idée reçue fort préjudiciable, selon laquelle « génétique » serait synonyme de « fatalité ». Au contraire, ces découvertes sont porteuses d’espoir, notamment à travers des applications comme les tests génétiques. Car identifier une vulnérabilité peut conduire à se mobiliser pour éviter le déclenchement e ectif du trouble ou individualiser sa prise en charge : « La connaissance de l’anomalie génétique devient une force et un levier pour une psychiatrie moderne, qui allie prévention, adaptation des soins, concertation avec les familles et les autres spécialités », s’enthousiasme l’auteur. Qui n’oublie pas de discuter les nombreux et complexes enjeux éthiques que posent ces applications… Guillaume Fond est psychiatre et responsable du Centre expert schizophrénie aux hôpitaux universitaires de Marseille.

COGNITION
Qu’est-ce que l’intelligence ? Héloïse Lhérété (dir.) Éditions Sciences Humaines 2024, 320 pages, 22 €
Comment l’intelligence se développe-t-elle chez les enfants ? En existe-t-il une ou plusieurs formes ? Que dire de celle des surdoués (ou HPI) ? Et des IA, et des animaux, voire des plantes ? Au gré de chapitres courts et agréables à lire, les experts réunis dans cet ouvrage o rent un large angle de vue pour répondre à toutes les questions que l’on se pose sur l’intelligence. Le lecteur en ressort avec un certain nombre de réponses concrètes – par exemple sur l’intérêt de faire sauter une classe à un enfant surdoué –, tout en ayant acquis de passionnantes connaissances sur l’ancrage cérébral de nos facultés cognitives.

NEUROSCIENCES
Deux têtes
Uta Frith et al. Denoël 2024, 352 pages, 32 €
Voilà le livre idéal pour une première plongée dans l’univers des neurosciences. Les principales découvertes de ces dernières années y sont racontées en bande dessinée, qu’elles portent sur le fonctionnement d’un cerveau individuel ou sur les rouages psychologiques et neuronaux de la coopération. L’ouvrage est riche, fouillé, tout en restant accessible et ludique grâce à son format graphique et à son choix narratif : la mise en scène d’un couple de neuroscientifiques mondialement renommés, Uta et Chris Frith, qui relatent cette histoire en même temps que leurs vies de chercheurs.

ÉDUCATION
Science et école : ensemble pour mieux apprendre Stanislas Dehaene (dir.) Odile Jacob 2024, 320 pages, 22,90 €
Comment favoriser l’acquisition des savoirs fondamentaux portant par exemple sur le langage, l’écriture ou les mathématiques ? C’est ce qu’explore ce nouvel opus résumant les travaux du Conseil scientifique de l’Éducation nationale. L’ouvrage se veut résolument pratique et se fonde sur un discours argumenté, avec un souci constant de l’évaluation et de la preuve, ainsi qu’un ancrage dans les enquêtes de terrain sur les résultats des élèves. À mettre entre les mains de tous les enseignants, mais aussi des parents, qui y trouveront de nombreux conseils savamment étayés.

NEUROSCIENCES
Pourquoi nous rêvons
Rahul Jandial Leduc 2024, 336 pages, 21 €
Les rêves ne sont pas l’apanage des poètes, ils font aussi l’objet d’une science fascinante que Rahul Jandial, neurochirurgien et chercheur en neurosciences, raconte ici avec brio. Expliquant les bienfaits supposés des songes, les pistes pour les interpréter ou les façons de lutter contre les cauchemars, il appuie sa réflexion sur une vaste synthèse des recherches publiées, mais aussi, de façon plus inattendue, sur son expérience de médecin. Il cite ainsi le cas d’Anna : un kyste modifiait l’activité de son cerveau de telle sorte que celle-ci ressemblait à l’activité cérébrale observée pendant les rêves.
Résultat : Anna débordait de créativité !

DÉVELOPPEMENT DE L’ENFANT
La Santé mentale de mon enfant Beth Mosley Eyrolles, 2024, 372 pages, 24 €
l y a au moins deux bonnes raisons d’accorder une attention particulière à la santé mentale des enfants et des jeunes aujourd’hui. D’une part, elle s’est nettement dégradée depuis la pandémie de Covid-19. D’autre part, elle constitue une base de départ qui influence durablement le devenir des individus, puisque les recherches montrent que 50 % des problèmes de santé mentale apparaissent avant l’âge de 15 ans. Dans ce contexte, le rôle des adultes est fondamental, comme nous l’explique Beth Mosley, psychologue clinicienne qui accompagne les familles depuis plus de deux décennies. Ce livre présente une série de méthodes et d’outils validés scientifiquement pour prendre soin des enfants… et des parents ! À travers son expérience clinique et son propre vécu de maman, l’autrice dépeint les cas de figure di ciles les plus fréquemment rencontrés : harcèlement scolaire, famille éclatée, omniprésence des écrans… Sans donner l’impression qu’il existe des recettes miracles valables pour tout le monde, elle fournit de vraies pistes pour a ronter ces situations. À commencer par l’attention accordée au réseau social, premier facteur de protection de la santé mentale : on aura ainsi tout intérêt à consolider les liens sécurisants de l’enfant au sein de sa famille et avec d’autres adultes, tout en l’aidant à cultiver ses amitiés. Sont également expliqués le rôle du sommeil, de l’activité physique, de l’alimentation et des écrans dans les problèmes d’anxiété ou d’humeur. Les multiples encadrés parachèvent le côté pratique, en proposant des activités à mener en famille et des outils pour développer certaines compétences, comme la communication ou la confiance en soi. Très agréable à lire et facile d’accès, cet ouvrage o rira donc un grand bol d’air à tous les éducateurs – parents, professeurs, soignants… – qui s’imaginent que les problèmes rencontrés avec les enfants sont sans issue. De par son ton bienveillant et soutenant, il devrait en outre leur épargner deux écueils : la culpabilisation systématique face aux inévitables manquements et une quête de la perfection aussi épuisante que stérile.
Rebecca Shankland est professeuse en psychologie du développement à l’université Lyon 2.


Docteur en neurosciences, auteur, enseignant et chercheur à l’université de Fribourg, en Suisse.
Des humains rangeant des boîtes à des endroits précis en exécutant les ordres de machines ?
Cette réalité est celle de certaines multinationales.
Elle était anticipée dès 1978 par ce récit autobiographique du sociologue Robert Linhart.
«Nous ne sommes pas des robots ! » Par ce slogan, les grévistes de l’entreprise Amazon revendiquaient non seulement des droits et des salaires décents, mais surtout la simple prise en compte de leur humanité. Dans ces gigantesques hangars où tout est géré par des algorithmes, le moindre de leurs gestes est ordonné et chronométré par une entité artifcielle dont ils ne savent rien, faisant de leur corps et de leur esprit l’équivalent d’un bras robotisé. Triste ironie : on croyait que les machines allaient remplacer les humains, et fnalement on demande aux humains d’obéir à des machines… Cette tendance à une gestion du travail de plus en plus informatisée et rationalisée se répand partout : dans l’industrie du détail, la livraison, les transports, l’hôtellerie, les centres d’appels… Mais avec quelles répercussions sur notre psychologie et notre santé mentale ? Si
£ En 1978, Robert Linart décrit dans L’Établi les conséquences délétères de la rationalisation excessive du travail dans une chaîne de montage de voitures.
£ Ce dispositif contrevient à un besoin psychologique fondamental humain : l’autodétermination. Mais il s’est longtemps heurté à des limites techniques.
£ Aujourd’hui, l’intelligence artificielle permet de pousser à l’extrême ce type d’organisation.
nous manquons encore de recul pour évaluer ces aspects, les expériences passées sont riches d’enseignements. De fait, ce qui est présenté comme l’intrusion du big data, de l’intelligence artifcielle et de l’automatisation dans nos vies professionnelles n’est pas si différent d’anciennes tentatives pour contrôler et surveiller le travail des employés, sous couvert d’améliorer scientifquement leurs performances.
UN TÉMOIGNAGE POIGNANT
Un des témoignages les plus poignants sur le sujet date de 1978, quand fut publié L’Établi, de Robert Linhart. Peu de temps après les événements de mai 68, Linhart, alors fraîchement diplômé et militant maoïste, se fait engager dans une usine Citroën, à la porte de Choisy, à Paris, comme ouvrier spécialisé – ou O.S. Il s’agissait pour des étudiants, des intellectuels et des militants de
gauche de « s’établir » dans les entreprises, autrement dit d’aller sur le terrain, en clandestinité, pour enquêter sur les conditions de vie des ouvriers, mais également par solidarité et en signe de refus de leur destin tout tracé de bourgeois.
Linhart découvre alors avec effarement la dure réalité de la chaîne de montage. Au-delà des odeurs, de la chaleur, du bruit, des échardes, des produits toxiques, de la répétition, de la fatigue et du sentiment permanent d’être dans un « bocal », il éprouve ce que signife le fait d’être mis entièrement au service d’une machinerie abstraite. Pourtant, au milieu de ce cauchemar déshumanisant, les hommes tentent malgré tout de s’approprier leur activité et de faire « à leur manière ». L’exemple le plus frappant vient vers la fn du récit, sous les traits d’un ouvrier nommé Demarcy, qui s’est fabriqué un singulier établi (voir l’extrait) – c’est là le second sens du titre du roman. Certes, ses méthodes ne répondent
à aucune norme, mais Demarcy fait figure de légende dans l’usine Citroën-Choisy. Il a sa propre technique pour chaque cas particulier, qui lui permet de régler nombre de défauts et d’imprévus à une vitesse imbattable. Tout le monde le respecte, et le laisse opérer sa magie dans son coin avec admiration.
FONDAMENTAUX
Le contraste entre Demarcy et le reste de l’usine illustre à merveille l’absurdité de la rationalisation excessive du travail, et la négation de la créativité humaine à laquelle elle conduit. Il révèle en particulier l’importance du concept psychologique d’autodétermination. Selon une théorie échafaudée dans les années 1980 par les chercheurs américains Richard Ryan et Edward Deci, et corroborée depuis par de solides confrmations expérimentales, la motivation humaine dépend essentiellement de trois besoins : la compétence, l’autonomie et les
Tout est déterminé par un algorithme opaque qui dicte ses ordres à l’employé selon une logique inaccessible à l’esprit humain.
relations sociales. Ces trois besoins satisfaits, les individus se portent mieux, sont plus performants et s’engagent davantage dans leurs tâches. La motivation « s’internalise » : c’est-à-dire qu’elle s’ancre dans l’individu et ne dépend plus entièrement de facteurs, contraintes ou contrôles externes. Les psychologues du travail ont même inventé le terme de job crafting pour décrire la tendance, souvent tacite et parfois clandestine, qu’ont les employés à remodeler leur travail, de façon à mieux aligner leur quotidien, leurs méthodes et leurs objectifs sur leurs intérêts et compétences personnelles. Les effets sur le bien-être au travail sont alors avérés.
Ceretoucheur de portières est un Français. Un homme à cheveux blancs, méticuleux, dont j’observe avec admiration les gestes habiles. On dirait un petit artisan, et il paraît presque déplacé, oublié comme un vestige d’une autre époque dans l’enchaînement répété des mouvements de l’atelier. […]
Le plus étonnant, c’est son établi. Un engin indéfinissable, fait de morceaux de ferraille et de tiges, de supports hétéroclites, d’étaux improvisés pour caler les pièces, avec des trous partout et une allure d’instabilité inquiétante. Ce n’est qu’une apparence. Jamais l’établi ne l’a trahi ni ne s’est e ondré. Et, quand on le regarde travailler pendant un temps assez long, on comprend que toutes les apparentes imperfections de l’établi ont leur utilité : par cette fente, il peut glisser un instrument qui servira à caler une partie cachée ; par ce trou, il passera la tige d’une soudure di cile ; par cet espace vide, en dessous – qui rend l’ensemble si fragile d’apparence –, il pourra faire un complément de martelage sans avoir à retourner la portière déjà calée. Cet établi bricolé, il l’a confectionné lui-même, modifié, transformé, complété. Maintenant, il fait corps avec, il en connaît les ressources par cœur. L’Établi, de Robert Linhart, 1978, Minuit, pp. 162-163.
Respecté, libre, créatif, passionné et expert, Demarcy semble embrasser la théorie de l’autodétermination et le principe du job crafting à la lettre. Et pourtant, un jour, on lui impose… un nouvel établi standardisé. Et là, il y perd non seulement son effcacité, mais aussi sa confance, son calme et sa dignité : « Des années d’habitude, de gestes connus par cœur, d’expérience, bousillées d’un coup » par des responsables invisibles du « bureau des méthodes » qui ne l’ont jamais rencontré. Peu de temps après, on apprend que Demarcy tombe malade. L’organisation répressive de la chaîne de fabrication a fnalement eu raison de sa résistance. L’épuisement, le racisme, les menaces, les divisions, les humiliations, la routine, les mouchards, un sentiment permanent de
peur, tout semble mis en place au millimètre pour dissuader toute velléité de révolte : « L’usine est conçue pour produire des objets et broyer des hommes. »
UN « UNIVERS
SEMI-PÉNITENTIAIRE »
Comment en arrive-t-on à une telle situation ? Outre le capitalisme, les patrons et les surveillants, Linhart souligne le rôle des scientifiques dans l’élaboration de cet enfer. Dès le début du XX e siècle, l’ingénieur américain Frederick Winslow Taylor a proposé d’optimiser scientifquement la performance individuelle par l’élimination rationnelle de toutes les actions superfues. Une telle vision ne s’arrêtait d’ailleurs pas au monde de l’entreprise, mais devait selon lui s’appliquer à l’agriculture, à la fnance, au gouvernement, à l’éducation, jusqu’à l’Église et à la gestion de nos vies sociale et familiale.
Ce projet posait toutefois deux types de problème. D’une part, l’application stricte du taylorisme était impossible : on ne pouvait pas, d’un point de vue pratique, chronométrer et mesurer chaque geste de chaque employé, et imposer à tous la même efficacité. D’autre part, dès les années 1920, une série d’expériences menées à l’usine Hawthorne de la compagnie Western Electric remit en cause la pertinence de cette organisation hyperrationalisée, en montrant que l’attention apportée aux employés et à leur satisfaction au travail avait plus d’influence sur leurs performances que les variables objectives de leur environnement (cadence, luminosité, etc.). Ainsi, le taylorisme est devenu synonyme de tentatives de rationalisations abstraites qui ne tiennent aucun compte des réalités humaines et matérielles. Hélas, les nouvelles technologies ont aujourd’hui rendu possible l’instauration de ce programme, et les erreurs se répètent. Les outils de surveillance mis en place sont effrayants. L’entreprise Sociometric Solutions, rebaptisée depuis Humanyze, dont
Pourquoi j’ai aimé ce livre

L’expérience d’un intellectuel infiltré dans un milieu ouvrier pourrait laisser craindre une forme de voyeurisme malsain, et Robert Linhart n’était que trop conscient des dangers de sa démarche. Son récit, au contraire, révèle une sensibilité touchante, ainsi qu’une remarquable humilité face à ses infortunés collègues. Il en ressort un tableau lucide et sans concession. Entre solidarité et conflits, enthousiasme et désespoir, révolte et routine, L’Établi est d’une telle densité humaine qu’il va bien au-delà de la simple enquête et se dévore comme un authentique roman.
Sebastian Dieguez
H. Konuk et al., The e ect of digitalized workplace on employees’ psychological wellbeing : Digital taylorism approach, Technology in Society, 2023.
A. Delfanti, Machinic dispossession and augmented despotism : Digital work in an Amazon warehouse, New Media & Society, 2019
C. O’Neill, Taylorism, the european science of work, and the quantified self at work, Science, Technology & Human Values, 2017
G. Slemp et al., Workplace well-being : The role of job crafting and autonomy support, Psychology of WellBeing, 2015
la Bank of America et diverses entreprises pharmaceutiques sont clientes, a par exemple développé des badges d’entreprise munis de capteurs permettant d’identifer à qui parle un employé, pendant combien de temps, sur quel ton et à quelle vitesse. Dans les entrepôts d’Amazon, le système va si loin que les travailleurs n’ont plus aucune prise sur l’organisation effective des marchandises. Tout est déterminé par un algorithme opaque qui dicte ses ordres à l’employé via un écran ou une oreillette, lui intimant de ranger les objets selon une logique inaccessible à l’esprit humain, uniquement perméable à l’algorithme, au point de produire ce qu’on appelle un « rangement chaotique »… Tout au long de ce processus, plus besoin d’échanger des informations avec les collègues : il sufft de remplir les exigences d’un supercalculateur !
Finalement, l’entreprise a déposé des brevets pour des lunettes augmentées qui indiqueraient directement à l’employé dans quelle direction se rendre, à quelle vitesse et quel objet saisir. Autonomie, sentiment de compétence, liens sociaux… tous les principes de l’autodétermination sont piétinés, avec des effets dévastateurs : dans les centres d’appels hypersurveillés, plusieurs enquêtes journalistiques ont révélé une grande détresse et une anxiété omniprésente, qui se traduisent par un turnover démentiel des travailleurs. Le cas de Demarcy est un douloureux rappel… Bien sûr, les motivations personnelles des travailleurs entrent parfois en confit avec les exigences des employeurs, patrons et actionnaires. Bien sûr, ces divergences sont source de heurts et parfois de ralentissements. Mais l’alternative d’un contrôle total de l’individu est-elle préférable ? Et plutôt que de se préoccuper uniquement de rendement et de performance, la science du travail ne devrait-elle pas surtout viser au bien-être et à la dignité des individus et des sociétés ? £
Lors d’une tête au football, le cerveau ricoche parfois dans la boîte crânienne. Les neurones sont alors étirés, ce qui peut perturber leurs connexions et le flux de messagers chimiques qu’ils s’échangent.
Certains individus brillants, après avoir eu le prix Nobel, se mettent à dérailler et à avancer des théories fumeuses sans aucune preuve. Un syndrome qui voit le souci de l’esprit critique balayé par le sentiment d’être intellectuellement supérieur, voire infaillible.
Les câlins auraient un effet positif avéré sur la santé mentale et physique, faisant notamment baisser les taux de cortisol, une hormone du stress. Les chercheurs ont découvert que cet effet ne dépend pas de qui donne le câlin, il peut s’agir d’un(e) inconnu(e). Le plus important serait d’en recevoir souvent, et ils n’ont pas besoin d’être très longs.
« Le microbiote intestinal pourrait contribuer aux di érences de comportement social dans la population générale. » Katerina Johnson, biologiste à l’université d’Oxford.
des criminels auraient eu une enfance marquée par l’inceste, ou posséderaient un cas dans leur famille au cours des générations précédentes.
À la puberté, la sueur des ados dégage une concentration élevée d’acides carboxyliques, des molécules associées à des odeurs fortes d’herbe coupée, de fromage ou de musc de chèvre, une sécrétion très odorante produite durant la période du rut par une glande située sous l’abdomen de l’animal.
Les individus de type passif-agressif seraient des personnes qui auraient longtemps subi les agissements des autres. Au bout d’un moment, quand la situation s’y prête, ils se libéreraient et basculeraient vers des comportements de revendication parfois véhéments.
Les crises d’épilepsie provoquées par les électrochocs dans le cerveau des patients feraient reculer les symptômes dépressifs dans 50 % à 70 % des cas.














































4e édition Québec

Sénégal

15 conférences, ateliers, interviews En ligne & gratuit du 20 au 27 mai



















